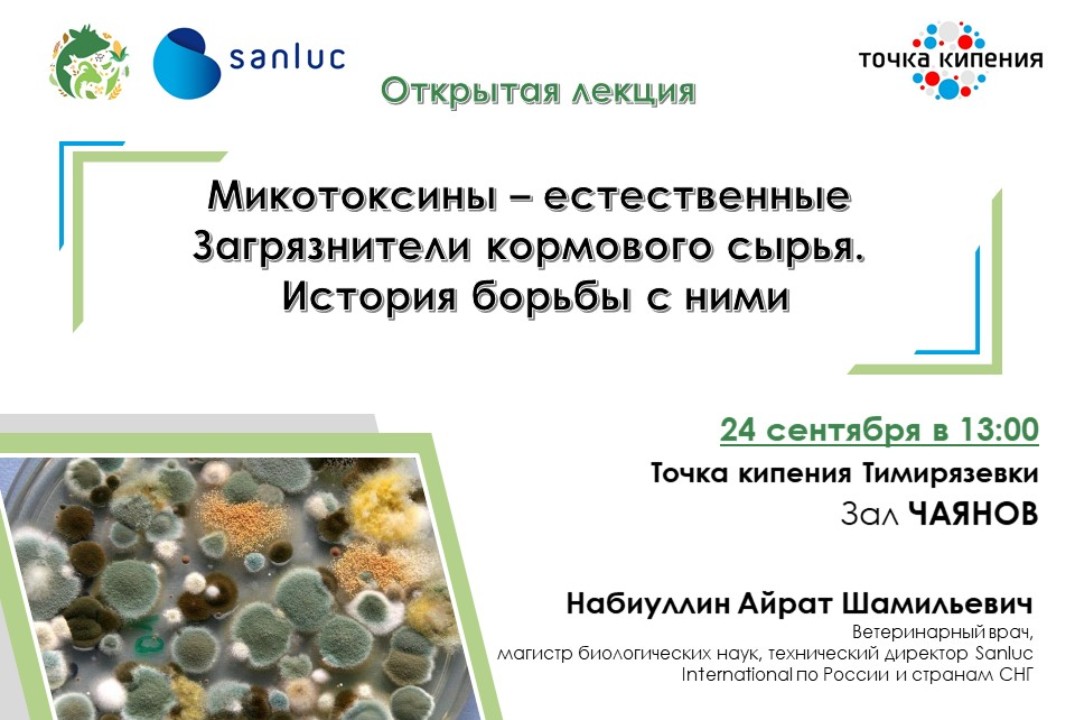
Микотоксины - естественные загрязнители кормового сырья....

Анжелика Александровна Ксенофонтова
Доцент • ФГБОУ ВО "Российский государственный аграрный университет - МСХА имени К.А.Тимирязева"
2814873
Ксенофонтова
Анжелика
Александровна
Доцент • ФГБОУ ВО "Российский государственный аграрный университет - МСХА имени К.А.Тимирязева"
Русский
Интересы:
Промышленность
Сельское хозяйство
Экономика
Инновации
Наука и исследования
Экология
HealthNet
FoodNet
TechNet
EduNet
Карьера
Основное
ФГБОУ ВО "Российский государственный аграрный университет - МСХА имени К.А.Тимирязева"
Доцент
Достижения
Будущий технолидер
Успешно завершил акселерационную программу в рамках Платформы технологического университетского предпринимательства в 2022 году
Посетил 20 мероприятий
За прошедший год вы посетили 20 мероприятий!
Достижения

Образование
Пользователь не заполнил информацию об образовании
Резюме
Пользователь скрыл информацию
Дополнительно
Знание языков:
Русский
Активность
Прошедшие мероприятия
Интересы
ПромышленностьСельское хозяйствоЭкономикаИнновацииНаука и исследованияЭкологияHealthNetFoodNetTechNetEduNet
Проекты
#50515
Участник
Мобильное приложение Equiwel для превентивной оценки уровня благополучия лошадей
уже идут:


Команды
Нет команд для отображения